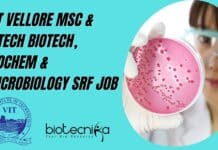
VIT Vellore MSc & MTech Biotech, Biochem & Microbiology SRF Job VIT Vellore SRF 2022

Biotecnika Times Newsletter 15.11.2022 Govt Internship With Stipend, DBT-inStem Doctoral Programme 2022
Biotecnika Times Newsletter 15.11.2022 Govt Internship With Stipend, DBT-inStem Doctoral Programme 2022
Govt Food Safety Intern Recruitment With Monthly Stipend of Rs. 10,000 pm, Apply...
THSTI Life Sciences Job For MSc & PhD Candidates, Applications Invited
THSTI Job Openings 2022 For Life Sciences, Applications Invited
THSTI Job Openings 2022 For Life Sciences, Applications Invited. MSc & PhD Life Sciences jobs. Interested...
NIMHANS Microbiology & Virology Research Fellow Recruitment
NIMHANS Virology Job 2022 - SRF Vacancy Available
NIMHANS Virology Job 2022 - SRF Vacancy Available. MSc Virology/ Microbiology/ Medical Microbiology vacancy. MSc job at...
Govt Food Safety Intern Recruitment With Monthly Stipend of Rs. 10,000 pm, Apply Online
Govt Food Safety Intern Recruitment With Monthly Stipend of Rs. 10,000 pm, Apply Online
Govt Food Safety Intern Recruitment With Monthly Stipend of Rs....
National Institute of Immunology MSc & MTech Life Sciences SRF Job
NII Project SRF 2022 For MSc & MTech Life Sciences Candidates
NII Project SRF 2022 For MSc & MTech Life Sciences Candidates. MSc & MTech...
VIT Vellore MSc & MTech Biotech, Biochem & Microbiology SRF Job
VIT Vellore SRF 2022 Opening For MSc & MTech Candidates
VIT Vellore SRF 2022 Opening For MSc & MTech Candidates. MSc Biochemistry, Microbiology, Biotechnology SRF...
CSIR-National Institute of Oceanography MSc, MTech Biotech, Microbiology Multiple Research Jobs
CSIR-NIO Research Jobs For MSc, MTech Biotech, Microbiology
CSIR-NIO Research Jobs For MSc, MTech Biotech, Microbiology. CSIR-National Institute of Oceanography MTech Biotechnology Jobs. MSc Biotechnology...
DBT-inStem Doctoral Programme 2022 – Online Application Process
DBT-inStem Doctoral Programme 2022 - Online Application Process
DBT-inStem Doctoral Programme 2022 - Online Application Process. Advertisement for DBT-inStem Doctoral Programme-2022. Interested and eligible applicants can...
Institute of Life Sciences Research Associate Job With Rs. 47,000 pm Pay
ILS PhD Opening 2022 For Biotech & Life Sciences - Apply Online
ILS PhD Opening 2022 For Biotech & Life Sciences - Apply Online. PhD...
Life Sciences Medical Writer Job Opening at Labcorp, Apply Online
Life Sciences Medical Writer Job Opening at Labcorp, Apply Online
Life Sciences Medical Writer Job Opening at Labcorp, Apply Online. Medical Writing job opening. Labcorp...
ICAR-Indian Institute of Rice Research BSc & MSc Research Job Openings
ICAR-IIRR BSc & MSc Research Job Openings For Life Sciences
ICAR-IIRR BSc & MSc Research Job Openings For Life Sciences. ICAR-Indian Institute of Rice Research...
IISc Biological Sciences Instructor With Rs. 54,000 pm Pay, Apply Online
IISc Biological Sciences Instructor With Rs. 54,000 pm Pay, Apply Online
IISc Biological Sciences Instructor With Rs. 54,000 pm Pay, Apply Online. IISc Instructors jobs....
Gene Editing CRISPR Technologies MSc & MTech Life Sciences Project JRF
RCB Project JRF Post For MSc & MTech Candidates, Apply Online
RCB Project JRF Post For MSc & MTech Candidates, Apply Online. MSc & MTech...
Biotecnika Times Newsletter 14.11.2022 IISc Hiring Teaching Professionals, Traineeship With Fellowship, FAST
Biotecnika Times Newsletter 14.11.2022 IISc Hiring Teaching Professionals, Traineeship With Fellowship, FAST
IISc Life Sciences Teaching Assistant Recruitment, Apply Online
IISc Life Sciences Teaching Assistant Recruitment,...
BITS Pilani Hyderabad JRF Job For MSc, MTech, PhD & BE Candidates
BITS Pilani Hyderabad JRF 2022 For MTech Candidates, Applications Invited
BITS Pilani Hyderabad JRF 2022 For MTech Candidates, Applications Invited. MSc & MTech Biotech, Bioinformatics...